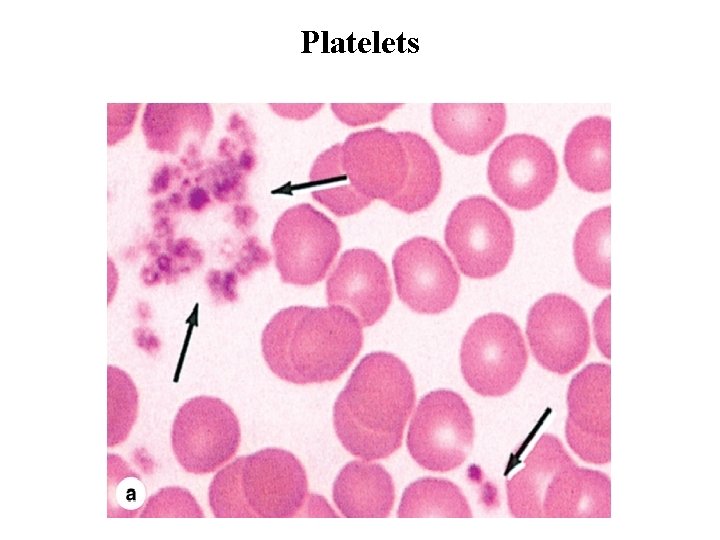
Platelets

Chapter 12 Blood Blood Blood is a specialized

Chapter 12. Blood

Blood • Blood is a specialized connective tissue in which cells are suspended in fluid extracellular material called plasma. • Propelled mainly by rhythmic contractions of the heart. • About five liters of blood in an average adult moves unidirectionally within the closed circulatory system. • The so-called formed elements circulating in the plasma are erythrocytes (red blood cells), leukocytes (white blood cells) and platelets.

Blood • When blood leaves the circulatory system plasma proteins react with one another to produce a clot, which includes formed elements and a yellowish liquid called serum. • Serum contains growth factors and other proteins released from platelets during clot formation, which confer biological properties very different from those of plasma. • Collected blood in which clotting is prevented by the addition of anticoagulants (eg, heparin, citrate) can be separated by centrifugation into layers that reflect its heterogeneity.

Hematocrit • Erythrocytes make up the bottom layer and their volume, normally about 45% of the total blood volume in healthy adults, is called the hematocrit. • The yellowish translucent, slightly viscous supernatant comprising 55% at the top half of the centrifugation tube is the plasma. • A thin layer between the plasma and the hematocrit, about 1% of the volume, is white or grayish in color and consists of leukocytes and platelets, both less dense than erythrocytes.

Composition of whole blood

Functions of the Blood • Blood is a distributing vehicle, transporting O 2, CO 2, metabolites, hormones, and other substances to cells throughout the body. • O 2 is bound mainly to hemoglobin in erythrocytes. • While CO 2 is carried in solution as CO 2 or HCO 3–, in addition to being hemoglobin bound. • • Nutrients are distributed from their sites of synthesis or absorption in the gut and metabolic residues are collected from all cells and removed from the blood by the excretory organs. • • Hormone distribution in blood permits the exchange of chemical messages between distant organs for normal cellular function. • Blood further participates in heat distribution, the regulation of body temperature, and the maintenance of acid-base and osmotic balance.

Functions of Leukocytes • Leukocytes have diversified functions and are one of the body's chief defenses against infection. • These cells are generally spherical and inactive while suspended in circulating blood, but when called to sites of infection or inflammation they cross the wall of venules, migrate into the tissues, and display their defensive capabilities.

Composition of Plasma • Plasma is an aqueous solution, p. H 7. 4, containing substances of low or high molecular weight that make up 8– 10% of its volume. • Plasma proteins account for approximately 7% of the dissolved components, with the remainder including nutrients nitrogenous waste products, hormones, and many inorganic ions collectively called electrolytes. • The major plasma proteins include the following: • Albumin. • Globulins. • Complement proteins. • Fibrinogen

Blood Cells • Blood cells are generally studied in smears or films prepared by spreading a drop of blood in a thin layer on a microscope slide. • Blood smears are routinely stained with special mixtures of acidic (eosin) and basic (methylene blue) dyes. These mixtures also contain dyes called azures that are more useful in staining cytoplasmic granules containing charged proteins and proteoglycans. • Azurophilic granules produce metachromasia in stained leukocytes like that seen with mast cells. Some of these special stains, such as Giemsa and Wright stain, are named for hematologists who introduced their own modifications into the original mixture.

Preparing a blood smear.

Erythrocytes • Erythrocytes (red blood cells) are terminally differentiated, lack nuclei, and are packed with the O 2 -carrying protein hemoglobin. • Under normal conditions, these corpuscles never leave the circulatory system. • Red blood cells suspended in an isotonic medium are flexible biconcave disks. • They are approximately 7. 5 m in diameter, 2. 6 m thick at the rim, and only 0. 75 m thick in the center. • This biconcave shape provides a large surface-to-volume ratio and facilitates gas exchange. • The normal concentration of erythrocytes in blood is approximately 3. 9– 5. 5 million per microliter in women and 4. 1– 6 million per microliter in men.

Erythrocytes

Normal human erythrocytes

Erythrocytes • The plasmalemma of the erythrocyte consists of about 40% lipid, 10% carbohydrate, and 50% protein. Most of the latter are integral membrane proteins, including ion channels, the anion transporter. • The glycosylated extracellular domains of these proteins include antigenic sites that form the basis for blood typing. • Several peripheral proteins are associated with the inner surface of the membrane, including spectrin, and ankyrin. These proteins permit the membrane and cell flexibility required for passage through capillaries and important for the normal low viscosity of blood.

Erythrocytes • Erythrocyte cytoplasm is densely filled with hemoglobin, the tetrameric O 2 -carrying protein. When combined with O 2 or CO 2, hemoglobin forms oxyhemoglobin or carbaminohemoglobin, respectively. The reversibility of these combinations is the basis for the gas-transporting capability of hemoglobin. • The combination of hemoglobin with carbon monoxide (CO) is irreversible, however, reducing the cells' capacity to transport O 2. • Human erythrocytes normally survive in the circulation for about 120 days. By this time defects in the membrane's cytoskeletal appears. • Worn-out erythrocytes displaying such changes are removed from the circulation, mainly by macrophages of the spleen, liver, and bone marrow.

Leukocytes • Leukocytes (white blood cells) migrate to the tissues where they become functional and perform various activities. • According to the type of cytoplasmic granules and the shape of their nuclei, leukocytes are divided into two groups: polymorphonuclear granulocytes and mononuclear agranulocytes. • Both types are spherical while suspended in blood plasma, but become amoeboid and motile after leaving the blood vessels and invading the tissues.

Leukocytes • All leukocytes are key players in the defense against invading microorganisms, and in the repair of injured tissues. In a process called diapedesis leukocytes leave the circulation and become active at the specific sites where needed has been especially well-studied for neutrophils, the most abundant leukocyte specially adapted for bacteria removal. • The attraction of neutrophils to bacteria involves chemical mediators in a process of chemotaxis, which causes leukocytes to rapidly concentrate where their defensive actions are specifically needed. • The number of leukocytes in the blood varies according to age, sex, and physiologic conditions. In healthy adults, there are roughly 6000– 10, 000 leukocytes per microliter of blood.

Leukocytes

Granulocytes • Granulocytes possess two types of granules: the specific granules that bind neutral, basic, or acidic stains and have specific functions and the azurophilic granules, which are specialized lysosomes, stain darkly, and are present at some level in all leukocytes. • When the cells phagocytose microorganisms, several azurophilic granule proteins act collectively to kill and then digest them. • Granulocytes have polymorphic nuclei with two or more lobes and include the neutrophils, eosinophils, and basophils. • All granulocytes are terminally differentiated cells with a life span of only a few days.

Agranulocytes • Agranulocytes do not have specific granules, but they do contain azurophilic granules (lysosomes). • The nucleus is round or indented. This group includes lymphocytes and monocytes.

Neutrophils (Polymorphonuclear Leukocytes) • Neutrophils constitute 60– 70% of circulating leukocytes. • They are 12– 15 m in diameter in blood smears, with nuclei having two to five lobes linked by thin nuclear extensions. • The cytoplasm of the neutrophil contains two main types of granules: the more abundant specific granules, which are very small and near the limit of light microscope resolution, and azurophilic granules, which are specialized lysosomes with components to kill ingested bacteria. • Neutrophils are short-lived cells with a half-life of 6– 7 hours in blood and a life span of 1– 4 days in connective tissues before dying by apoptosis.

Neutrophils (Polymorphonuclear Leukocytes)

Neutrophils (Polymorphonuclear Leukocytes)

Micrograph shows a neutrophil from a female in which the condensed X chromosome appears as a drumstick appendage to a nuclear lobe

Neutrophil ultrastructure.

Eosinophils • Eosinophils are far less numerous than neutrophils, constituting only 2– 4% of leukocytes in normal blood. • In blood smears, this cell is about the same size as a neutrophil, but with a characteristic bilobed nucleus. • The main identifying characteristic is the abundance of large, red specific granules (about 200 per cell) that are stained by eosin. • Ultrastructurally the eosinophilic specific granules are seen to be oval in shape, with many having a flattened crystalline core containing major basic protein. • This protein constitutes 50% of the total granule protein. The major basic protein, along with eosinophilic peroxidase, other enzymes and toxins, have cytotoxic effects on parasites such as helminthic worms and protozoa. • Eosinophils also phagocytose antigen-antibody complexes and modulate inflammatory responses in many ways. They are an important source of the factors mediating allergic reactions and asthma.

Eosinophils

Eosinophils

Sectioned Eosinophil

Basophils • Basophils are also about 12– 15 m in diameter, but make up less than 1%. • The nucleus is divided into two or more irregular lobes, but the large specific granules overlying the nucleus usually obscure its shape. • The azurophilic specific granules (0. 5 m in diameter) stain dark blue. Basophilic specific granules also contain much histamine and various mediators of inflammation. • Both basophils and mast cells have metachromatic granules containing heparin and histamine, have Ig. E bound to surface receptors, and secrete their granular components in response to certain antigens.

Basophils

Basophils

Sectioned Basophil

Lymphocytes • Lymphocytes constitute a family of leukocytes with spherical nuclei. • They can be subdivided into functional groups according to distinctive surface molecules (markers) into: T lymphocytes, B lymphocytes, and natural killer (NK) cells. • Lymphocytes have diverse functional roles related to immune defense against invading microorganisms, foreign or abnormal antigens, and cancer cells. • Most lymphocytes in the blood are small with diameters of 6– 8 m; medium and large lymphocytes range in size from 9 to 18 m in diameter. Some larger lymphocytes may be cells that have been activated by specific antigens.

Lymphocytes • The small lymphocytes that predominate in the blood are characterized by spherical nuclei, sometimes indented, and condensed, very basophilic chromatin, making them easily distinguishable from granulocytes. • The cytoplasm of the small lymphocyte is scanty, and in blood smears it appears as only a thin rim around the nucleus. It is slightly basophilic and may contain a few azurophilic granules, along with a few mitochondria and a small Golgi apparatus; it contains free polyribosomes. • Lymphocytes vary in life span according to their specific functions; some live only a few days and others survive in the circulating blood or other tissues for many years. They are the only type of leukocytes that, following diapedesis, can return from the tissues back to the blood.

Lymphocytes

Ultrastructurally a medium-sized lymphocytes

Monocytes • Monocytes are bone marrow–derived agranulocytes with diameters varying from 12 to 20 m. • The nucleus is large, off-center, and may be oval, kidney-shaped, or distinctly U-shaped. • The chromatin is less condensed than in lymphocytes and stains lighter than that of large lymphocytes. • The cytoplasm of the monocyte is basophilic and contains very small azurophilic granules (lysosomes), some of which are at the limit of the light microscope's resolution • Circulating monocytes are precursor cells of the mononuclear phagocyte system. After crossing the walls of postcapillary venules, monocytes differentiate into macrophages in connective tissues, microglia in the CNS, osteoclasts in bone, etc. •

Monocytes

Sectioned monocyte

Platelets • Blood platelets (thrombocytes) are nonnucleated, disklike cell fragments 2– 4 m in diameter. • Platelets originate by fragmentation at the ends of cytoplasmic processes extending from giant polyploid cells called megakaryocytes in the bone marrow. • Platelets promote blood clotting and help repair minor tears or leaks in the walls of blood vessels, preventing loss of blood. • Normal platelet counts range from 200, 000 to 400, 000 per microliter of blood. • Platelets have a life span of about 10 days. • In stained blood smears, platelets often appear in clumps. • Each platelet has a lightly stained peripheral zone, the hyalomere, and a central zone containing darker-staining granules, called the granulomere.
Platelets

Platelets • A coat rich in GAGs and glycoproteins, 15– 20 nm thick, lies outside the plasmalemma and is involved in platelet adhesion. • The Hyalomere are two systems of membrane channels: • An open canalicular system of vesicles connected to invaginations of the plasma membrane, which may facilitate platelets' uptake of factors such as fibrinogen and serotonin from plasma. • Another set of irregular tubular vesicles comprising the dense tubular system is derived from the ER and stores Ca 2+ ions. Together these two membranous systems facilitate the extremely rapid exocytosis of proteins from platelets (degranulation) upon adhesion to collagen or other substrates outside the vascular endothelium.

Platelets • The central Granulomere possesses a variety of membrane-bound granules: • Electron-dense Delta granules contains ADP, ATP and serotonin. • Alpha granules are larger and contain platelet-derived growth factor. Most of the stained granules seen with the light microscope in platelets are alpha granules. • Lambda granules are small vesicles have been shown to contain only lysosomal enzymes.

Ultra structure of platelet

The end
- Slides: 46